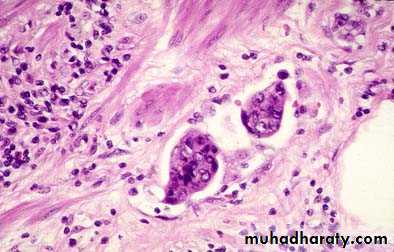

Pathology of the small and large intestine
Abdominal HerniaAny weakness or defect in the wall of the peritoneal cavity may permit protrusion of a serosa-lined pouch of peritoneum called a hernia sac.
Acquired hernias most commonly occur anteriorly, through the inguinal and femoral canals or umbilicus, or at sites of surgical scars. These are of concern because of visceral protrusion (external herniation).
Inguinal hernias
It tend to have narrow orifices and large sacs. Small bowel loops are herniated most often, but portions of omentum or large bowel also protrude, and any of these may become entrapped.Pressure at the neck of the pouch may impair venous drainage, leading to stasis and edema. These changes increase the bulk of the herniated loop, leading to permanent entrapment and over time, arterial and venous compromise, or strangulation, can result in infarction.
Vascular disorders of bowel
The greater portion of the gastrointestinal tract is supplied by the celiac, superior mesenteric, and inferior mesenteric arteries.As they approach the intestinal wall, the superior and inferior mesenteric arteries fan out to form the mesenteric arcades.
Interconnections between arcades, as well as collateral supplies from the proximal celiac and distal pudendal and iliac circulations, make it possible for the small intestine and colon to tolerate slowly progressive loss of the blood supply from one artery.
By contrast, acute compromise of any major vessel can lead to infarction of several meters of intestine.
Ischemic bowel disease
Ischemic damage to the bowel wall can range from mucosal infarction, extending no deeper than the muscularis mucosa; to mural infarction of mucosa and submucosa; to transmural infarction involving all three layers of the wall.Mucosal or mural infarctions often are secondary to acute or chronic hypoperfusion, transmural infarction is generally caused by acute vascular obstruction.
Causes of acute arterial obstruction
Severe atherosclerosis (which is often prominent at the origin of mesenteric vessels), aortic aneurysm.
Hypercoagulable states, oral contraceptive use.
Embolization of cardiac vegetations or aortic atheromas.
Causes of intestinal hypoperfusion
Cardiac failure.
Shock.
Dehydration.
Vasoconstrictive drugs.
Damage intestinal arteries
Systemic vasculitides, such as polyarteritis nodosum, Henoch-Shonlein purpura, or Wegener granulomatosis.
PATHOGENESIS
Intestinal responses to ischemia occur in two phases.The initial hypoxic injury occurs at the onset of vascular compromise and, although some damage occurs, intestinal epithelial cells are relatively resistant to transient hypoxia.
The second phase, reperfusion injury, is initiated by restoration of the blood supply and associated with the greatest damage. In severe cases multiorgan failure may occur. While the underlying mechanisms of reperfusion injury are incompletely understood, they involve free radical production, neutrophil infiltration, and release of inflammatory mediators, such as complement proteins and cytokines.
The severity of vascular compromise, time frame during which it develops, and vessels affected are the major variables that determine severity of ischemic bowel disease.
Tumors of the small and large intestine:
Non neoplastic polyp:Adenoma:
Familial polyposis syndrome:
Colorectal carcinoma:
Gastrointestinal lymphoma:
GIST:
Polyps
Polyps are most common in the colon but may occur in the esophagus, stomach, or small intestine.
sessile, grow directly from the stem without a stalk.
pedunculated Polyps with stalks.
Intestinal polyps can be classified as non-neoplastic or neoplastic in nature.
The most common neoplastic polyp is the adenoma, which has the potential to progress to cancer.
The non-neoplastic polyps can be classified as inflammatory, hamartomatous, or hyperplastic.
Inflammatory polyps
Solitary rectal ulcer syndrome.Patients present with a clinical triad of rectal bleeding, mucus discharge, and an inflammatory lesion of the anterior rectal wall.
The underlying cause is impaired relaxation of the anorectal sphincter that creates a sharp angle at the anterior rectal shelf and leads to recurrent abrasion and ulceration of the overlying rectal mucosa. An inflammatory polyp may ultimately form as a result of chronic cycles of injury and healing.
Entrapment of this polyp in the fecal stream leads to mucosal prolapse.
Histologic features:
Inflammatory polyp with superimposed mucosal prolapse and include lamina propria fibromuscular hyperplasia, mixed inflammatory infiltrates, erosion, and epithelial hyperplasia.
Solitary rectal ulcer syndrome.
A, The dilated glands, proliferative epithelium, superficial erosions, and inflammatory infiltrate are typical of an inflamatory polyp.The smooth muscle hyperplasia within the lamina propria suggests that mucosal prolapse has also occurred.B, Epithelial hyperplasia.
C, Granulation tissue-like capillary proliferation within the lamina propria caused by repeated erosion and re-epithelialization
Hamartomatous polyps
It’s occur sporadically and in the context of various genetically determined or acquired syndromes.
Hamartomas are tumor-like growths composed of mature tissues that are normally present at the site in which they develop.
Hamartomatous polyposis syndromes are rare, they are important to recognize because of associated intestinal and extra-intestinal manifestations and the possibility that other family members are affected.
Hyperplastic polyps
Common epithelial proliferations.Discovered in the sixth and seventh decades of life.
Pathogenesis of hyperplastic polyps is incompletely understood, but they are thought to result from decreased epithelial cell turnover and delayed shedding of surface epithelial cells, leading to a “piling up” of goblet cells and absorptive cells.
These lesions are without malignant potential.
they must be distinguished from sessile serrated adenomas, histologically similar lesions that have malignant potential.
It is also important to remember that epithelial hyperplasia can occur as a nonspecific reaction adjacent to or overlying any mass or inflammatory lesion and, therefore, can be a clue to the presence of an adjacent, clinically important lesion.
Morphology
Gross:Hyperplastic polyps are most commonly found in the left colon and are typically less than 5 mm in diameter.
They are smooth, nodular protrusions of the mucosa, often on the crests of mucosal folds.
Single or multiple, particularly in the sigmoid colon and rectum.
Microscopically:
Hyperplastic polyps are composed of mature goblet and absorptive cells.
The delayed shedding of these cells leads to crowding that creates the serrated surface architecture that is the morphologic hallmark of these lesions.
Adenomatous Polypsepithelial proliferation and dysplasia
Four types: tubular, villous, mixed, and sessile serrated adenoma.
Risk of malignancy related to size, histologic type, and dysplasia
Since they are considered premalignant, all should be removed.Large pedunculated adenomatous colonic polyp
Hyperchromatic, test-tube shaped glands
from adenomatous colon polypColorectal adenocarcinoma
• NSAID have protective effects.Colon Adenocarcinoma
• Right colon:• increasing incidence, especially in elderly
• usually polypoid
• present with bleeding, anemia
• Left colon:
• annular, napkin ring lesions
• present with decreased stool caliber, obstruction
• Less than half of cancers are detectable by proctoscopic exam
Molecular model for the evolution of colorectal cancers through the adenoma-carcinoma sequence.
Although APC mutation is an early event and loss of p53 occurs late in the process of tumorigenesis, the timing for the other changes may be variable.
Note: individual tumors may not have all of the changes listed.
Top right, cells that gain oncogene signaling without loss of p53 eventually enter oncogene-induced senescence
• Function
• Type• Locus
• Gene
• Regulate intracellular
• b-catenin levels Proliferation/
• apoptosis/cell
• adhesion
• Gate keeper
• Tumor suppressor
• 5q
• APC
• Membrane associated
• G protein
• Growth factor signal
• transduction
• Oncogene
• 12P
• K RAS
• TGF-b signaling
• pathway
• Growth inhibition
• signal transduction
• Tumor suppressor
• 18q
• SMAD 2,4
• Cell interactions/
• adhesion
• Apoptosis
• Tumor suppressor
• 18q
• DCC
• Cell cycle checkpoint
• Apoptosis
• Tumor suppressor
• 17p
• P53
• Morphology of colonic adenocarcinoma:
• Gross:
• Site: 25% in the cecum &ascending colon, 25% in the descending colon and proximal sigmoid, the remaining scattered elsewhere.
• Polypoid growth in the proximal.
• Annual encirculing lesion in distal colon.
• Microscopically:
Hereditary Colon Cancer Sy.
• Familial Adenomatous Polyposis• autosomal dominant
• mutation in APC gene on 5q21
• 100-2500 polyps throughout GI tract
• virtually 100% risk of carcinoma
• HNPCC (Lynch Syndrome)
• autosomal dominant
• increased risk of GI and non-GI cancers
• lower numbers of polyps than FAP
• Hereditary Syndromes Involving the Gastrointestinal Tract
• Pathology in GI Tract• Altered Gene
• Syndromes
• Multiple adenomatous polyps
• APC
• Familial adenomatous polyposis (FAP)
• • Classic FAP
• • Attenuated FAP
• • Gardner syndrome
• • Turcot syndrome
• Hamartomatous polyps
• STK11
• Peutz-Jeghers syndrome
• Juvenile polyps
• SMAD4
• Juvenile polyposis syndrome
• BMPRIA
• Colon cancer
• Defects in mismatch DNA repair genes
• Hereditary nonpolyposis colorectal carcinoma
• Inflammatory polyps
• TSC1
• Tuberous sclerosis
• TSC2
• Hamartomatous polyps
• PTEN
• Cowden disease
Constricting “napkin ring” Ca
Large Fungating Ca Colon:
Carcinoma Colon
Cribriform malignant glands
Lymphatic invasion
Tumors of the Anal CanalThe anal canal can be divided into thirds. The upper zone is lined by columnar rectal epithelium; the middle third by transitional epithelium; and the lower third by stratified squamous epithelium. Carcinomas of the anal canal may have typical glandular or squamous patterns of differentiation, recapitulating the normal epithelium of the upper and lower thirds, respectively. An additional differentiation pattern, termed basaloid, is present in tumors populated by immature cells derived from the basal layer of transitional epithelium. When the entire tumor displays a basaloid pattern, the archaic term cloacogenic carcinoma is still often applied.
Basaloid differentiation may be mixed with squamous or mucinous differentiation. All are considered variants of anal canal carcinoma. Pure squamous cell carcinoma of the anal canal is frequently associated with HPV infection, which also causes precursor lesions such as condyloma accuminatum.
Carcinoid Tumors-pathology
Solitary or multicentric firm, yellow-tan nodulesUsually submucosal masses, sometimes with ulceration
Cause striking desmoplastic response
Form islands, trabeculae, glands, or sheets
Monotonous, speckled nuclei and abundant pink cytoplasm
Contain cytoplasmic secretory dense-core granules
Carcinoid tumor of the appendix
Nests of carcinoid tumor cells
Gastrointestinal LymphomaMost common primary extranodal lymphoma location
Sporadic/Western type-most common.
Thought to arise from Mucosal Associated Lymphoid Tissues
Controversial relationship with H. pylori
T-cell lymphomas associated with celiac sprue
Intestinal B-cell lymphoma
FleshyLymphatic tumor
Neoplastic lymphatic follicles
GISTApproximately 75% to 80% of all GISTs have oncogenic, gain-of-function mutations of the gene encoding the tyrosine kinase c-KIT, which is the receptor for stem cell factor. Another 8% of GISTs have mutations that activate a related tyrosine kinase, platelet-derived growth factor receptor A (PDGFRA); thus activating mutations in tyrosine kinases are found in virtually all GISTs. However, either mutation is sufficient for tumorigenesis, and c-KIT and PDGFRA mutations are almost never found in a single tumor.
GISTs appear to arise from, or share a common stem cell with, the interstitial cells of Cajal, which express c-KIT, are located in the muscularis propria, and serve as pacemaker cells for gut peristalsis.
MORPHOLOGY
Primary gastric GISTs usually form a solitary, well circumscribed,fleshy, submucosal mass. Metastases may form multiple small serosal nodules or fewer large nodules in the liver; spread outside of the abdomen is uncommon.
GISTs can be composed of thin, elongated spindle cells or plumper epithelioid cells. The most useful diagnostic marker is c-KIT, consistent with the relationship between GISTs and interstitial cells of Cajal, which is immunohistochemically detectable in 95% of these tumors.
Clinical Features
Symptoms of GISTs at presentation may be related to mass effects or mucosal ulceration. Complete surgical resection is the primary treatment for localized gastric GIST.The prognosis correlates with tumor size, mitotic index, and location, with gastric GISTs being somewhat less aggressive than those arising in the small intestine. Recurrence or metastasis is rare for gastric GISTs less than 5 cm across but common for mitotically active tumors larger than 10 cm.